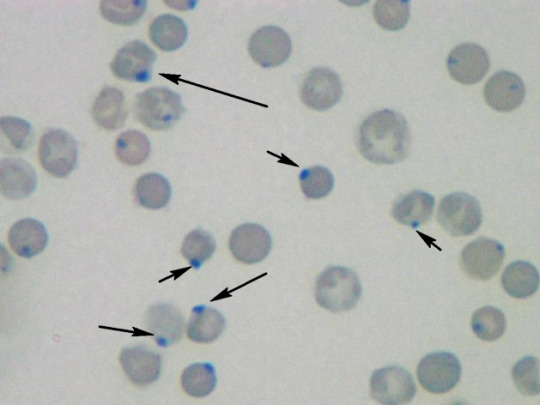

Hematology/Oncology
PAINE PANCE Postcard – Lead Poisoning
PAINE PANCE Postcard – Multiple Myeloma
PAINE PANCE Postcard – Hodgkin Lymphoma
PAINE PANCE Postcard – Acute Lymphoblastic Leukemia
Ep-PAINE-nym
Pemberton Sign
Other Known Aliases – none
Definition – Raising of the patient’s arms over their head (until the arms touch their face) causes flushing and congestion of head and neck due to venous congestion and thoracic inlet obstruction.

Clinical Significance – this is a simple physical examination maneuver to diagnose a patient with superior vena cava syndrome and pressure on the thoracic inlet. A positive sign is flushing and cyanosis of the head and neck with possible respiratory distress with prolonged holding and is associated with mediastinal masses, goiters, and mediastinal lymphadenopathy.
History – Named after Hugh Spear Pemberton (1890-1956), who was an English physician and recieved his medical doctorate from the University of Liverpool in 1913. He would subsequently serve as a physician in the Royal Medical Corp during World War I and returned to Liverpool at the David Lewis Northern Hospital where he would spend his entire career. He founded one of the first diabetic clinics there in 1922 and made a name for himself in he area of endocrinology and receiving Fellowship in the Royal College of Physicians in 1941. It was in 1946 that he published a very short letter to the Lancet describing his eponymous maneuver.
References
- Firkin BG and Whitwirth JA. Dictionary of Medical Eponyms. 2nd ed. New York, NY; Parthenon Publishing Group. 1996.
- Bartolucci S, Forbis P. Stedman’s Medical Eponyms. 2nd ed. Baltimore, MD; LWW. 2005.
- Yee AJ, Pfiffner P. (2012). Medical Eponyms (Version 1.4.2) [Mobile Application Software]. Retrieved http://itunes.apple.com.
- Whonamedit – dictionary of medical eponyms. http://www.whonamedit.com
- Up To Date. www.uptodate.com
- Pemberton HS. SIGN OF SUBMERGED GOITRE The Lancet. 1946; 248(6423):509 [link]
- De Filippis EA, Sabet A, Sun MRM, Garber JR. Pemberton’s Sign: Explained Nearly 70 Years Later . 2014; 99(6):1949-1954 [link]
Ep-PAINE-nym
Heinz Bodies
Other Known Aliases – Heinz-Ehrlich bodies, Ehrlich Inner Body
Definition – Deep purple small irregular bodies in red cells stained with crystal violet which represents denatured hemoglobin due to oxidative damage.
Clinical Significance – Seen in conditions with high oxidative stress such as G6PD deficiency, alpha thalassemia, NADPH deficiency, chronic liver disease, and asplenia.
History – Named after Robert Heinz (1865-1924), a German physician and pharmcologist who recieved his medical doctorate from the University of Breslau in 1888. He would work in the university chemical laboratory in Jena and Munich throughout his career studying pathology, inflammation, degeneration, and regeneration of blood. It was during this time, specifically in 1890, that he published a study on the blood of guinea pigs treated with acetylphenylhydrazine to intoduce oxidative inflammation and identified his eponymous cellular structure. Of note, Paul Ehrlich (1854-1915) is also regionally credited with identifying this structure but did not formally publish his findings.
References
- Firkin BG and Whitwirth JA. Dictionary of Medical Eponyms. 2nd ed. New York, NY; Parthenon Publishing Group. 1996.
- Bartolucci S, Forbis P. Stedman’s Medical Eponyms. 2nd ed. Baltimore, MD; LWW. 2005.
- Yee AJ, Pfiffner P. (2012). Medical Eponyms (Version 1.4.2) [Mobile Application Software]. Retrieved http://itunes.apple.com.
- Whonamedit – dictionary of medical eponyms. http://www.whonamedit.com
- Up To Date. www.uptodate.com
- R. Heinz. Morphologische Veränderungen des roten Blutkörperchens durch Gifte. [Virchows] Archiv für pathologische Anatomie und Physiologie und für klinische Medizin, Berlin, 1890, 122: 112-116
Ep-PAINE-nym
von Willebrand Disease
Other Known Aliases – hereditary pseudohemophilia
Definition – Autosomal dominant, hereditary clotting disorder arising from a deficiency in the quantity and/or quality of von Willebrand factor (vWF), which is a protein required for platelet adhesion and involved in primary hemostasis. The genetic defect responsible for vWF production the vWF gene located on the short arm of chromosome 12 (12p13.2)

Clinical Significance – This is the most common type of hereditary blood-clotting disorder in humans, with 3 main hereditary types and multiple subtypes. Type 1 is the most common and often asymptomatic, Type 2 can have mild to moderate symptoms, Type 3 is the most severe and can manifest with hemarthosis and internal bleeding.
History – Named after Erik Adolf von Willebrand (1870-1949), a Finnish physician who received his medical doctorate from the University of Helsinki 1896, and who took a special interest in hematology and coagulation. In 1924, a 5yo girl was brought to him due to a bleeding disorder and he successfully performed a family history map on the girl’s 66 living family members and discovered the autosomal dominant pattern. He published his findings in 1926 in Swedish calling it “pseudo-hemophilia”, but it wasn’t until 1931 (when it was translated into German) did it gain any traction in the medical community.



References
- Firkin BG and Whitwirth JA. Dictionary of Medical Eponyms. 2nd ed. New York, NY; Parthenon Publishing Group. 1996.
- Bartolucci S, Forbis P. Stedman’s Medical Eponyms. 2nd ed. Baltimore, MD; LWW. 2005.
- Yee AJ, Pfiffner P. (2012). Medical Eponyms (Version 1.4.2) [Mobile Application Software]. Retrieved http://itunes.apple.com.
- Whonamedit – dictionary of medical eponyms. http://www.whonamedit.com
- Up To Date. www.uptodate.com
- Von Willebrand EA. Hereditary pseudohaemophilia. Haemophilia. 1999; 5(3):223-31. [translation of original paper] [pubmed]
- Leebeek FW, Eikenboom JC. Von Willebrand’s Disease. NEJM. 2016; 375(21):2067-2080. [pubmed]
- Nilsson IM. Commentary to Erik von Willebrand’s original paper from 1926 ‘Hereditär pseudohemofili’. Haemophilia. 1999; 5(3):220-1. [pubmed]
Ep-PAINE-nym
Blumer’s Shelf
Other Known Aliases – rectal shelf
Definition – shelf-like tumor of the anterior rectal wall (Pouch of Douglas) felt on rectal examination

Clinical Significance – palpation of this “shelf” indicates implantation metastases from primary abdominal malignancy
History – Names after George Blumer (1872-1962), who was an English-American physician and recieved his medical doctorate from the Cooper Medical College (forerunner of Stanford’s medical school) in 1891. He would go onto to train under William Halstead and William Osler at Johns Hopkins Hospital at house officer. In 1906, he became professor of medicine at Yale culminating in Dean of the medical school from 1910-1920. It was during this tenure (1909) when he described his eponymous finding in an article entitled “Rectal shelf: neglected rectal sign of value in diagnosis of obscure malignant and inflammatory disease within the abdomen”.
References
- Firkin BG and Whitwirth JA. Dictionary of Medical Eponyms. 2nd ed. New York, NY; Parthenon Publishing Group. 1996.
- Bartolucci S, Forbis P. Stedman’s Medical Eponyms. 2nd ed. Baltimore, MD; LWW. 2005.
- Yee AJ, Pfiffner P. (2012). Medical Eponyms (Version 1.4.2) [Mobile Application Software]. Retrieved http://itunes.apple.com.
- Whonamedit – dictionary of medical eponyms. http://www.whonamedit.com
- Up To Date. www.uptodate.com
- Blumer G. Rectal shelf: neglected rectal sign of value in diagnosis of obscure malignant and inflammatory disease within the abdomen. Albany Medical Annals. 1909;30:361-366.
- Haubrich WS. Blumer of Blumer’s Shelf. Gastroenterology. 2000;118(1):30
#57 – Acute Myeloid Leukemia
***LISTEN TO THE PODCAST HERE***

Epidemiology
- Most common type of acute leukemia and the second most common type in adults
- 32% of all adult leukemia cases
- Only 1% of all adult cancers deaths in the US
- Around 12,000 deaths per year in US
- 3-5 cases per 100,000 population
- Around 20,000 patients per year in the US get diagnosed
- 2% annual increase in cases from 2007-2016
- Mean age of diagnosis is 65 years and increases with age


Pathophysiology
- Malignancy of myeloid precursor cells
- Multipotential hematopoietic stem cell –> common myeloid progenitor –> myeloblast

- 2 main models
- Occurs at one of several developmental stages
- Occurs within the primitive multipotent cells
- Two-hit hypothesis of leukemogenesis
- Class I mutation
- Confers a proliferative advantage
- Class II mutation
- Impairs hematopoietic differentiation
- Class I mutation
- Mechanisms of Genetic Damage
- Chemotherapy
- 3-5 years after alkylating agent-induced damage
- Ionizing radiation
- Induces double strand breaks
- Typically > 20 Gy (grays)
- Chemical exposure
- Benzene is classically associated with AML
- Infections
- Human T-lymphocyte virus type I (HTLV-1
- Chemotherapy
Signs and Symptoms
- Constitutional
- Fatigue, weakness, dyspnea
- Fever
- Skin (13% of patients)
- Easy bruisability, ecchymoses
- Pallor
- HEENT
- Gingival bleeding, oral candidiasis
- Papilledema, retinal infiltrates
- Lymphadenopathy
- Abdomen (10% of patients)
- Organomegaly
- Spleen and liver
- Organomegaly
- Musculoskeletal (4% of patients)
- Polyarthritis and arthralgias
- Bone pain
Emergency Presentations
- Pancytopenia
- Tumor lysis syndrome
- Hyperkalemia, hyperphosphatemia, hyperuricemia, AKI
- Bleeding
- New onset CNS symptoms
Diagnostic Studies
- CBC
- Leukocytosis or leukopenia
- 20% of patients have > 100,000 cells/microL
- 25-40% of patients have < 5,000 cells/microL
- Thrombocytopenia
- 75% of patients have < 100,000 cells/microL
- 25% of patient have < 25,000 cells/microL
- Leukocytosis or leukopenia
- Peripheral Blood
- 95% of patients will have circulating myeloblasts
- Immature cells with large, prominent nuclei and variable amount of pale blue cytoplasms
- May have Auer rods present
- Myeloperoxidase reaction
- Simple means of determining if the blasts are myeloid
- 95% of patients will have circulating myeloblasts

- Flow Cytometry
- Can assist in detecting circulating myeloblasts
- Bone Marrow Biopsy
- This is the key component in the diagnosis of AML
- It gives a general overview of the degree of involvement, allows for cell differential count to determine the percentage of blasts in the marrow, and provides a detailed cytologic evaluation of the blasts
- Cell Origin
- Identifies if myeloid, monocytic, erythroid, or megakaryocytic
- Differentiates the blasts of lymphoid lineage
- Infiltration
- Diagnosis of AML is > 20% blasts of the total cellularity
- HLA Typing in patients who are potential candidates for bone marrow transplantation
Diagnosis
- Requires both of the following criteria:
- Documentation of bone marrow infiltration
- > 20% blasts in bone morrow
- Myeloid origin
- Presence of Auer rods, (+) myeloperoxidase reaction, or presence of myeloid markers on immunophenotyping
- Documentation of bone marrow infiltration
Treatment
- Goals
- Complete remission (<5% blasts)
- Appropriate goal for most AML patients
- Complete remission (<5% blasts)
- Pretreatment evaluation
- Comorbid conditions
- Heart disease, renal insufficiency, liver disease
- Physical function and performance status
- ECOG Scale most commonly used
- Comorbid conditions

- Two distinct treatment phases
- Induction
- Combination therapy (7 and 3 regimen)
- Cytarabine
- Interferes with DNA synthesis
- 7 day continuous infusion
- Anthracycline
- Daunorubicin, idarubicin
- Inhibition of topoisomerase II
- Leads to DNA breaks
- Inhibition of topoisomerase II
- Day 1, 2, and 3
- Daunorubicin, idarubicin
- Cytarabine
- Bone marrow biopsy 7-10 days after induction to re-assess
- Combination therapy (7 and 3 regimen)
- Postremission management
- Continuing chemotherapy
- Hematopoietic cell transplant
- Induction
Prognosis
- Overall 5-year survival is 15%
- Decreases with age
- 53% 5-year survival in 15-24yo to 13% in 70-79yo
- Decreases with age
- Genetic subtypes
- Karyotypes
- Gene mutations
The Cottage Physician (1893)

References
- Acute myeloid leukemia statistics. Cancer.net. Accessed on 03/22/2020 [link]
- Blum W, Bloomfield CD. Acute Myeloid Leukemia. In: Jameson J, Fauci AS, Kasper DL, Hauser SL, Longo DL, Loscalzo J. eds. Harrison’s Principles of Internal Medicine, 20e New York, NY: McGraw-Hill; . http://accessmedicine.mhmedical.com.ezproxy.uthsc.edu/content.aspx?bookid=2129§ionid=192017732. Accessed March 22, 2020.
- Siegel RL, Miller KD, Jemal A. Cancer Statistics, 2017. CA: a cancer journal for clinicians. 2017; 67(1):7-30. [pubmed]
- Reilly JT. Pathogenesis of acute myeloid leukaemia and inv(16)(p13;q22): a paradigm for understanding leukaemogenesis? British journal of haematology. 2005; 128(1):18-34. [pubmed]
- Levine EG, Bloomfield CD. Leukemias and myelodysplastic syndromes secondary to drug, radiation, and environmental exposure. Seminars in oncology. 1992; 19(1):47-84. [pubmed]
- Shuryak I, Sachs RK, Hlatky L, Little MP, Hahnfeldt P, Brenner DJ. Radiation-induced leukemia at doses relevant to radiation therapy: modeling mechanisms and estimating risks. Journal of the National Cancer Institute. 2006; 98(24):1794-806. [pubmed]
- Austin H, Delzell E, Cole P. Benzene and leukemia. A review of the literature and a risk assessment. American journal of epidemiology. 1988; 127(3):419-39. [pubmed]
- Shah A, Andersson TM, Rachet B, Björkholm M, Lambert PC. Survival and cure of acute myeloid leukaemia in England, 1971-2006: a population-based study. British journal of haematology. 2013; 162(4):509-16. [pubmed]









